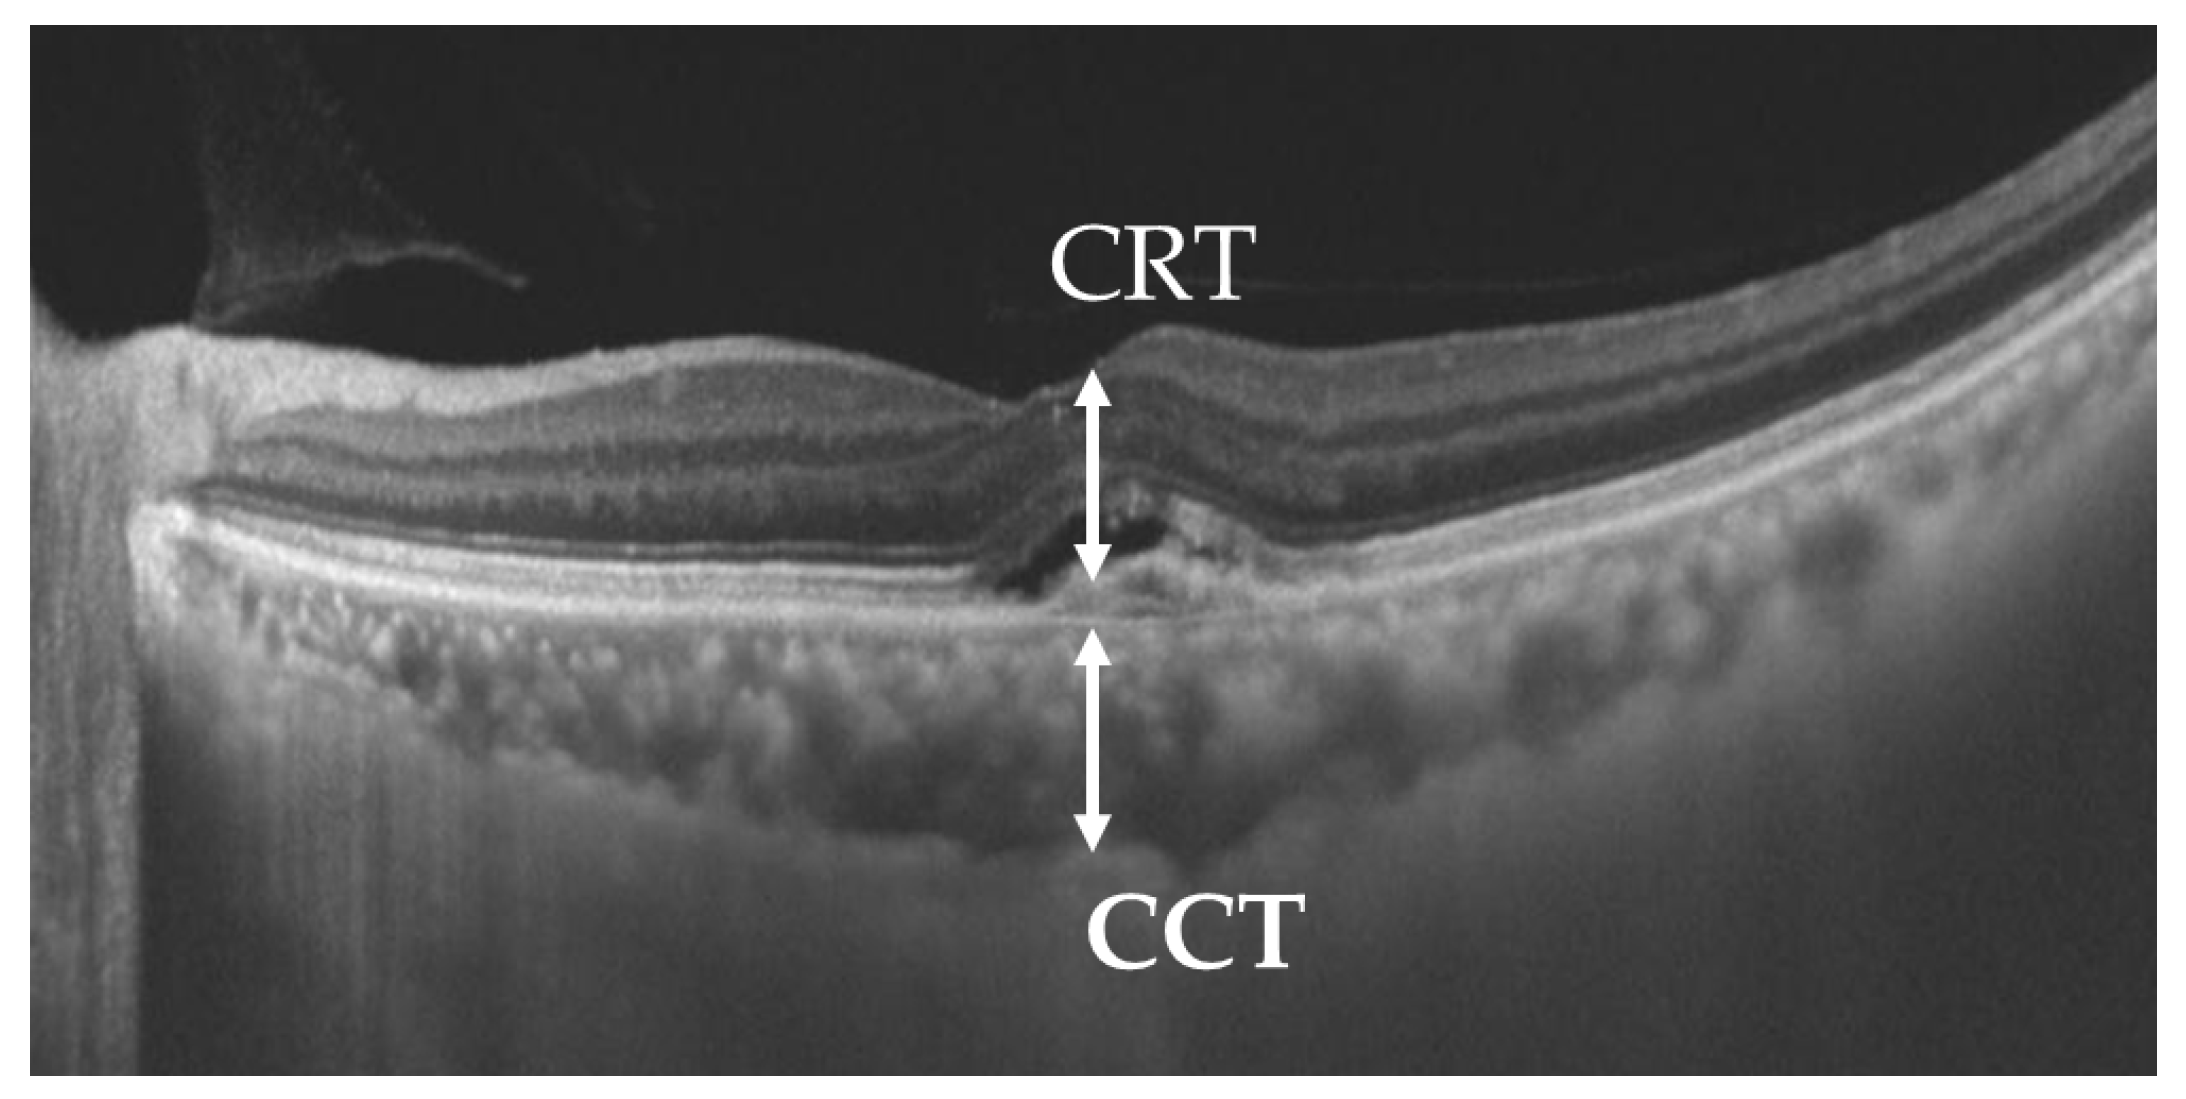
Jcm 13 06244 g002

Factors Affecting Visual Acuity After Anti-Vascular Endothelial Growth Factor Therapy in Neovascular Age-Related Macular Degeneration: A Multicenter Study in Japan
Abstract
1. Introduction
2. Materials and Methods
2.1. Study Design and Ethics
2.2. Patients
2.3. Research and Analysis
- Patient background factors: age, sex, AMD subtype (polypoidal choroidal vasculopathy [PCV], typical AMD [tAMD], or retinal angiomatous proliferation [RAP]), smoking history, diabetes, hypertension (HT), cardiovascular disease (CAVD), cerebrovascular disease (CEVD), and use of anticoagulants.
- Optical coherence tomography (OCT) and fundus findings: the presence or absence of subretinal fluid (SRF), intraretinal fluid (IRF), pigment epithelial detachment (PED), subretinal hyperreflective material (SHRM), epiretinal membrane (ERM), hard exudates (HE), and subretinal hemorrhage (SRH) was evaluated based on OCT images and fundus examination (Figure 1).
- 3.
- Thickness measurements: the central retinal thickness (CRT) and central choroidal thickness (CCT) were measured either automatically or manually using OCT depending on the imaging system (Figure 2). The CRT was measured from the internal limiting membrane to the retinal pigment epithelium, and the CCT was measured from the outer surface of the retinal pigment epithelium to the inner sclera.
- 4.
- Treatment-related factors: the type of drug (aflibercept or ranibizumab), the treatment regimen (pro re nata, modified treat and extend [modified TAE], TAE, or bimonthly), any changes in treatment (no change, drug switch, or combined with photodynamic therapy [PDT]), the number of intravitreal injections, and whether the treatment was maintained over the course of 1 year.
2.4. Statistical Analysis
3. Results
3.1. Patient Characteristics
3.2. Baseline CRT and CCT
3.3. Changes in BCVA
3.4. Association of Each Parameter with BCVA at 1 Year
3.5. Association Between CRT and OCT/Fundus Findings
4. Discussion
5. Conclusions
Author Contributions
Funding
Institutional Review Board Statement
Informed Consent Statement
Data Availability Statement
Acknowledgments
Conflicts of Interest
References
- Wong, W.L.; Su, X.; Li, X.; Cheung, C.M.; Klein, R.; Cheng, C.Y.; Wong, T.Y. Global prevalence of age-related macular degeneration and disease burden projection for 2020 and 2040: A systematic review and meta-analysis. Lancet Glob. Health 2014, 2, e106–e116. [Google Scholar] [CrossRef]
- Yasuda, M.; Kiyohara, Y.; Hata, Y.; Arakawa, S.; Yonemoto, K.; Doi, Y.; Iida, M.; Ishibashi, T. Nine-year incidence and risk factors for age-related macular degeneration in a defined Japanese population the Hisayama study. Ophthalmology 2009, 116, 2135–2140. [Google Scholar] [CrossRef]
- Flaxman, S.R.; Bourne, R.R.A.; Resnikoff, S.; Ackland, P.; Braithwaite, T.; Cicinelli, M.V.; Das, A.; Jonas, J.B.; Keeffe, J.; Kempen, J.H.; et al. Global causes of blindness and distance vision impairment 1990–2020: A systematic review and meta-analysis. Lancet. Glob. Health 2017, 5, e1221–e1234. [Google Scholar] [CrossRef]
- Morizane, Y.; Morimoto, N.; Fujiwara, A.; Kawasaki, R.; Yamashita, H.; Ogura, Y.; Shiraga, F. Incidence and causes of visual impairment in Japan: The first nation-wide complete enumeration survey of newly certified visually impaired individuals. Jpn. J. Ophthalmol. 2019, 63, 26–33. [Google Scholar] [CrossRef]
- Matoba, R.; Morimoto, N.; Kawasaki, R.; Fujiwara, M.; Kanenaga, K.; Yamashita, H.; Sakamoto, T.; Morizane, Y. A nationwide survey of newly certified visually impaired individuals in Japan for the fiscal year 2019: Impact of the revision of criteria for visual impairment certification. Jpn. J. Ophthalmol. 2023, 67, 346–352. [Google Scholar] [CrossRef]
- Brown, D.M.; Kaiser, P.K.; Michels, M.; Soubrane, G.; Heier, J.S.; Kim, R.Y.; Sy, J.P.; Schneider, S. Ranibizumab versus verteporfin for neovascular age-related macular degeneration. N. Engl. J. Med. 2006, 355, 1432–1444. [Google Scholar] [CrossRef]
- Rosenfeld, P.J.; Brown, D.M.; Heier, J.S.; Boyer, D.S.; Kaiser, P.K.; Chung, C.Y.; Kim, R.Y. Ranibizumab for neovascular age-related macular degeneration. N. Engl. J. Med. 2006, 355, 1419–1431. [Google Scholar] [CrossRef]
- Heier, J.S.; Brown, D.M.; Chong, V.; Korobelnik, J.F.; Kaiser, P.K.; Nguyen, Q.D.; Kirchhof, B.; Ho, A.; Ogura, Y.; Yancopoulos, G.D.; et al. Intravitreal aflibercept (VEGF trap-eye) in wet age-related macular degeneration. Ophthalmology 2012, 119, 2537–2548. [Google Scholar] [CrossRef]
- Dugel, P.U.; Koh, A.; Ogura, Y.; Jaffe, G.J.; Schmidt-Erfurth, U.; Brown, D.M.; Gomes, A.V.; Warburton, J.; Weichselberger, A.; Holz, F.G. HAWK and HARRIER: Phase 3, Multicenter, Randomized, Double-Masked Trials of Brolucizumab for Neovascular Age-Related Macular Degeneration. Ophthalmology 2020, 127, 72–84. [Google Scholar] [CrossRef] [PubMed]
- Khanani, A.M.; Guymer, R.H.; Basu, K.; Boston, H.; Heier, J.S.; Korobelnik, J.F.; Kotecha, A.; Lin, H.; Silverman, D.; Swaminathan, B.; et al. TENAYA and LUCERNE: Rationale and Design for the Phase 3 Clinical Trials of Faricimab for Neovascular Age-Related Macular Degeneration. Ophthalmol. Sci. 2021, 1, 100076. [Google Scholar] [CrossRef] [PubMed]
- Lanzetta, P.; Korobelnik, J.F.; Heier, J.S.; Leal, S.; Holz, F.G.; Clark, W.L.; Eichenbaum, D.; Iida, T.; Xiaodong, S.; Berliner, A.J.; et al. Intravitreal aflibercept 8 mg in neovascular age-related macular degeneration (PULSAR): 48-week results from a randomised, double-masked, non-inferiority, phase 3 trial. Lancet 2024, 403, 1141–1152. [Google Scholar] [CrossRef]
- Chew, E.Y.; Clemons, T.E.; Agrón, E.; Sperduto, R.D.; Sangiovanni, J.P.; Davis, M.D.; Ferris, F.L., 3rd. Ten-year follow-up of age-related macular degeneration in the age-related eye disease study: AREDS report no. 36. JAMA Ophthalmol. 2014, 132, 272–277. [Google Scholar] [CrossRef]
- Age-Related Eye Disease Study Research Group. A randomized, placebo-controlled, clinical trial of high-dose supplementation with vitamins C and E, beta carotene, and zinc for age-related macular degeneration and vision loss: AREDS report no. 8. Arch. Ophthalmol. 2001, 119, 1417–1436. [Google Scholar] [CrossRef]
- Age-Related Eye Disease Study 2 (AREDS2). Lutein + zeaxanthin and omega-3 fatty acids for age-related macular degeneration: The Age-Related Eye Disease Study 2 (AREDS2) randomized clinical trial. JAMA 2013, 309, 2005–2015. [Google Scholar] [CrossRef]
- Pameijer, E.M.; Heus, P.; Damen, J.A.A.; Spijker, R.; Hooft, L.; Ringens, P.J.; Imhof, S.M.; van Leeuwen, R. What did we learn in 35 years of research on nutrition and supplements for age-related macular degeneration: A systematic review. Acta Ophthalmol. 2022, 100, e1541–e1552. [Google Scholar] [CrossRef]
- Tan, J.S.; Mitchell, P.; Kifley, A.; Flood, V.; Smith, W.; Wang, J.J. Smoking and the long-term incidence of age-related macular degeneration: The Blue Mountains Eye Study. Arch. Ophthalmol. 2007, 125, 1089–1095. [Google Scholar] [CrossRef]
- Age-Related Eye Disease Study Research Group. Risk factors associated with age-related macular degeneration. A case-control study in the age-related eye disease study: Age-Related Eye Disease Study Report Number 3. Ophthalmology 2000, 107, 2224–2232. [Google Scholar] [CrossRef]
- Ghaem Maralani, H.; Tai, B.C.; Wong, T.Y.; Tai, E.S.; Li, J.; Wang, J.J.; Mitchell, P. Metabolic syndrome and risk of age-related macular degeneration. Retina 2015, 35, 459–466. [Google Scholar] [CrossRef]
- Clemons, T.E.; Milton, R.C.; Klein, R.; Seddon, J.M.; Ferris, F.L., 3rd. Risk factors for the incidence of Advanced Age-Related Macular Degeneration in the Age-Related Eye Disease Study (AREDS) AREDS report no. 19. Ophthalmology 2005, 112, 533–539. [Google Scholar] [CrossRef] [PubMed]
- Tan, J.S.; Mitchell, P.; Smith, W.; Wang, J.J. Cardiovascular risk factors and the long-term incidence of age-related macular degeneration: The Blue Mountains Eye Study. Ophthalmology 2007, 114, 1143–1150. [Google Scholar] [CrossRef]
- Fujiwara, K.; Yasuda, M.; Hata, J.; Oshima, Y.; Hashimoto, S.; Yoshitomi, T.; Kiyohara, Y.; Ishibashi, T.; Ninomiya, T.; Sonoda, K.H. Prevalence and Risk Factors for Polypoidal Choroidal Vasculopathy in a General Japanese Population: The Hisayama Study. Semin. Ophthalmol. 2018, 33, 813–819. [Google Scholar] [CrossRef]
- Kawasaki, R.; Wang, J.J.; Ji, G.J.; Taylor, B.; Oizumi, T.; Daimon, M.; Kato, T.; Kawata, S.; Kayama, T.; Tano, Y.; et al. Prevalence and risk factors for age-related macular degeneration in an adult Japanese population: The Funagata study. Ophthalmology 2008, 115, 1376–1381.e2. [Google Scholar] [CrossRef]
- Jaffe, G.J.; Ying, G.S.; Toth, C.A.; Daniel, E.; Grunwald, J.E.; Martin, D.F.; Maguire, M.G. Macular Morphology and Visual Acuity in Year Five of the Comparison of Age-related Macular Degeneration Treatments Trials. Ophthalmology 2019, 126, 252–260. [Google Scholar] [CrossRef]
- Sawada, T.; Yasukawa, T.; Imaizumi, H.; Matsubara, H.; Kimura, K.; Terasaki, H.; Ishikawa, H.; Murakami, T.; Takeuchi, M.; Mitamura, Y.; et al. Subtype prevalence and baseline visual acuity by age in Japanese patients with neovascular age-related macular degeneration. Jpn. J. Ophthalmol. 2023, 67, 149–155. [Google Scholar] [CrossRef]
- Lee, S.; Song, S.J.; Yu, H.G. Current smoking is associated with a poor visual acuity improvement after intravitreal ranibizumab therapy in patients with exudative age-related macular degeneration. J. Korean Med. Sci. 2013, 28, 769–774. [Google Scholar] [CrossRef]
- Piermarocchi, S.; Miotto, S.; Colavito, D.; Leon, A.; Segato, T. Combined effects of genetic and non-genetic risk factors affect response to ranibizumab in exudative age-related macular degeneration. Acta Ophthalmol. 2015, 93, e451–e457. [Google Scholar] [CrossRef]
- Takahashi, K.; Ogura, Y.; Ishibashi, T.; Shiraga, F.; Yuzawa, M. Treatment guidelines for age-related macular degeneration. Nippon. Ganka Gakkai Zasshi 2012, 116, 1150–1155. [Google Scholar]
- Maruko, I.; Iida, T.; Saito, M.; Nagayama, D.; Saito, K. Clinical characteristics of exudative age-related macular degeneration in Japanese patients. Am. J. Ophthalmol. 2007, 144, 15–22. [Google Scholar] [CrossRef]
- Mori, K.; Horie-Inoue, K.; Gehlbach, P.L.; Takita, H.; Kabasawa, S.; Kawasaki, I.; Ohkubo, T.; Kurihara, S.; Iizuka, H.; Miyashita, Y.; et al. Phenotype and genotype characteristics of age-related macular degeneration in a Japanese population. Ophthalmology 2010, 117, 928–938. [Google Scholar] [CrossRef] [PubMed]
- Cheung, C.M.G. Macular neovascularization and polypoidal choroidal vasculopathy: Phenotypic variations, pathogenic mechanisms and implications in management. Eye 2024, 38, 659–667. [Google Scholar] [CrossRef] [PubMed]
- Koizumi, H.; Yamagishi, T.; Yamazaki, T.; Kawasaki, R.; Kinoshita, S. Subfoveal choroidal thickness in typical age-related macular degeneration and polypoidal choroidal vasculopathy. Graefe’s Arch. Clin. Exp. Ophthalmol. 2011, 249, 1123–1128. [Google Scholar] [CrossRef] [PubMed]
- Chung, S.E.; Kang, S.W.; Lee, J.H.; Kim, Y.T. Choroidal thickness in polypoidal choroidal vasculopathy and exudative age-related macular degeneration. Ophthalmology 2011, 118, 840–845. [Google Scholar] [CrossRef]
- Kim, J.H.; Kim, J.R.; Kang, S.W.; Kim, S.J.; Ha, H.S. Thinner choroid and greater drusen extent in retinal angiomatous proliferation than in typical exudative age-related macular degeneration. Am. J. Ophthalmol. 2013, 155, 743–749. [Google Scholar] [CrossRef] [PubMed]
- Yamazaki, T.; Koizumi, H.; Yamagishi, T.; Kinoshita, S. Subfoveal choroidal thickness in retinal angiomatous proliferation. Retina 2014, 34, 1316–1322. [Google Scholar] [CrossRef]
- Ranganathan, P.; Pramesh, C.S.; Buyse, M. Common pitfalls in statistical analysis: “P” values, statistical significance and confidence intervals. Perspect Clin. Res. 2015, 6, 116–117. [Google Scholar] [CrossRef]
- Emma, R.; Caruso, M.; Campagna, D.; Pulvirenti, R.; Li Volti, G. The Impact of Tobacco Cigarettes, Vaping Products and Tobacco Heating Products on Oxidative Stress. Antioxidants 2022, 11, 1829. [Google Scholar] [CrossRef]
- Conklin, B.S.; Zhao, W.; Zhong, D.S.; Chen, C. Nicotine and cotinine up-regulate vascular endothelial growth factor expression in endothelial cells. Am. J. Pathol. 2002, 160, 413–418. [Google Scholar] [CrossRef] [PubMed]
- Suñer, I.J.; Espinosa-Heidmann, D.G.; Marin-Castano, M.E.; Hernandez, E.P.; Pereira-Simon, S.; Cousins, S.W. Nicotine increases size and severity of experimental choroidal neovascularization. Investig. Ophthalmol. Vis. Sci. 2004, 45, 311–317. [Google Scholar] [CrossRef]
- Ni Dhubhghaill, S.S.; Cahill, M.T.; Campbell, M.; Cassidy, L.; Humphries, M.M.; Humphries, P. The pathophysiology of cigarette smoking and age-related macular degeneration. Adv. Exp. Med. Biol. 2010, 664, 437–446. [Google Scholar] [CrossRef]
- Topouzis, F.; Anastasopoulos, E.; Augood, C.; Bentham, G.C.; Chakravarthy, U.; de Jong, P.T.; Rahu, M.; Seland, J.; Soubrane, G.; Tomazzoli, L.; et al. Association of diabetes with age-related macular degeneration in the EUREYE study. Br. J. Ophthalmol. 2009, 93, 1037–1041. [Google Scholar] [CrossRef]
- Boscia, G.; Bacherini, D.; Vujosevic, S.; Grassi, M.O.; Borrelli, E.; Giancipoli, E.; Landini, L.; Pignataro, M.; Alessio, G.; Boscia, F.; et al. Long-Term Impact of Diabetic Retinopathy on Response to Anti-VEGF Treatment in Neovascular AMD. Investig. Ophthalmol. Vis. Sci. 2024, 65, 6. [Google Scholar] [CrossRef] [PubMed]
- Viggiano, P.; Miere, A.; Borrelli, E.; Boscia, G.; Grassi, M.O.; Souied, E.H.; Alessio, G.; Boscia, F. The Impact of Diabetic Retinopathy on the Choriocapillaris in Neovascular AMD. Investig. Ophthalmol. Vis. Sci. 2023, 64, 32. [Google Scholar] [CrossRef]
- Lai, T.T.; Hsieh, Y.T.; Yang, C.M.; Ho, T.C.; Yang, C.H. Biomarkers of optical coherence tomography in evaluating the treatment outcomes of neovascular age-related macular degeneration: A real-world study. Sci. Rep. 2019, 9, 529. [Google Scholar] [CrossRef]
- Moraes, G.; Fu, D.J.; Wilson, M.; Khalid, H.; Wagner, S.K.; Korot, E.; Ferraz, D.; Faes, L.; Kelly, C.J.; Spitz, T.; et al. Quantitative Analysis of OCT for Neovascular Age-Related Macular Degeneration Using Deep Learning. Ophthalmology 2021, 128, 693–705. [Google Scholar] [CrossRef]
- Nagiel, A.; Freund, K.B.; Spaide, R.F.; Munch, I.C.; Larsen, M.; Sarraf, D. Mechanism of retinal pigment epithelium tear formation following intravitreal anti-vascular endothelial growth factor therapy revealed by spectral-domain optical coherence tomography. Am. J. Ophthalmol. 2013, 156, 981–988.e982. [Google Scholar] [CrossRef]
- Sarraf, D.; Khanani, A.M.; Sadda, S.R.; Chang, A.; Wong, D.T.; Kempf, A.S.; Saffar, I.; Tang, S.; Tadayoni, R. Pigment epithelial detachment thickness and variability affects visual outcomes in patients with neovascular age-related macular degeneration. Retina 2024, 44, 10–19. [Google Scholar] [CrossRef]
- Veritti, D.; Sarao, V.; Gonfiantini, M.; Rubinato, L.; Lanzetta, P. Faricimab in Neovascular AMD Complicated by Pigment Epithelium Detachment: An AI-Assisted Evaluation of Early Morphological Changes. Ophthalmol. Ther. 2024, 13, 2813–2824. [Google Scholar] [CrossRef]
- Ibrahim, F.N.I.; Teo, K.Y.C.; Tan, T.E.; Chan, H.H.; Chandrasekaran, P.R.; Lee, S.Y.; Tan, A.C.S.; Mathur, R.; Chan, C.M.; Sim, S.S.; et al. Initial experiences of switching to faricimab for neovascular age-related macular degeneration and polypoidal choroidal vasculopathy in an Asian population. Front. Ophthalmol. 2023, 3, 1346322. [Google Scholar] [CrossRef]
- Khanani, A.M.; Sadda, S.R.; Sarraf, D.; Tadayoni, R.; Wong, D.T.; Kempf, A.S.; Saffar, I.; Gedif, K.M.; Chang, A. Effect of brolucizumab and aflibercept on the maximum thickness of pigment epithelial detachments and sub-retinal pigment epitheliumfluid in HAWK and HARRIER. Ophthalmol. Retin. 2024, in press. [CrossRef]
- Willoughby, A.S.; Ying, G.S.; Toth, C.A.; Maguire, M.G.; Burns, R.E.; Grunwald, J.E.; Daniel, E.; Jaffe, G.J.; Williams, D.F.; Beardsley, S.; et al. Subretinal Hyperreflective Material in the Comparison of Age-Related Macular Degeneration Treatments Trials. Ophthalmology 2015, 122, 1846–1853.e5. [Google Scholar] [CrossRef]
- Waldstein, S.M.; Philip, A.M.; Leitner, R.; Simader, C.; Langs, G.; Gerendas, B.S.; Schmidt-Erfurth, U. Correlation of 3-Dimensionally Quantified Intraretinal and Subretinal Fluid With Visual Acuity in Neovascular Age-Related Macular Degeneration. JAMA Ophthalmol. 2016, 134, 182–190. [Google Scholar] [CrossRef]
- Kumar, J.B.; Stinnett, S.; Han, J.I.L.; Jaffe, G.J. Correlation of subretinal hyperreflective material morphology and visual acuity in neovascular age-related macular degeneration. Retina 2020, 40, 845–856. [Google Scholar] [CrossRef]
- Ando, M.; Kato, A.; Kimura, M.; Ogura, S.; Kuwayama, S.; Kominami, A.; Kuwayama, S.; Obayashi, T.; Ando, R.; Monoe, T.; et al. Effects of Combination Therapy with Intravitreal Ranibizumab and Tissue Plasminogen Activator for Neovascular Age-Related Macular Degeneration. J. Clin. Med. 2024, 13, 2417. [Google Scholar] [CrossRef]
- Sadda, S.; Sarraf, D.; Khanani, A.M.; Tadayoni, R.; Chang, A.A.; Saffar, I.; Gedif, K.; Wong, D.T. Comparative assessment of subretinal hyper-reflective material in patients treated with brolucizumab versus aflibercept in HAWK and HARRIER. Br. J. Ophthalmol. 2024, 108, 852–858. [Google Scholar] [CrossRef]
- Thornton, J.; Edwards, R.; Mitchell, P.; Harrison, R.A.; Buchan, I.; Kelly, S.P. Smoking and age-related macular degeneration: A review of association. Eye 2005, 19, 935–944. [Google Scholar] [CrossRef]
- Chew, E.Y.; Clemons, T.E.; Agrón, E.; Domalpally, A.; Keenan, T.D.L.; Vitale, S.; Weber, C.; Smith, D.C.; Christen, W.; AREDS2 Research Group; et al. Long-term Outcomes of Adding Lutein/Zeaxanthin and ω-3 Fatty Acids to the AREDS Supplements on Age-Related Macular Degeneration Progression: AREDS2 Report 28. JAMA Ophthalmol. 2022, 140, 692–698. [Google Scholar] [CrossRef]
- Lixi, F.; Vitiello, L.; Giannaccare, G. Marine Natural Products Rescuing the Eye: A Narrative Review. Mar. Drugs 2024, 22, 155. [Google Scholar] [CrossRef]
- D’Angelo, A.; Vitiello, L.; Gagliardi, V.; Salerno, G.; De Pascale, I.; Coppola, A.; Abbinante, G.; Pellegrino, A.; Giannaccare, G. The Role of Oral Supplementation for the Management of Age-Related Macular Degeneration: A Narrative Review. J. Pers. Med. 2024, 14, 653. [Google Scholar] [CrossRef]
- Chong, E.W.; Kreis, A.J.; Wong, T.Y.; Simpson, J.A.; Guymer, R.H. Alcohol consumption and the risk of age-related macular degeneration: A systematic review and meta-analysis. Am. J. Ophthalmol. 2008, 145, 707–715.e2. [Google Scholar] [CrossRef]
- Zhang, J.; Mitsuhashi, T.; Matsuo, T.; Yorifuji, T.; Hamada, J.; Liu, Y. Alcohol Consumption and Age-related Macular Degeneration: A Systematic Review and Dose-response Meta-analysis. Curr. Eye Res. 2021, 46, 1900–1907. [Google Scholar] [CrossRef]

| Total (n = 182) | PCV (n = 78) | tAMD (n = 97) | RAP (n = 7) | p Value | ||||||
|---|---|---|---|---|---|---|---|---|---|---|
| Age (years) | Mean ± SD | 75.0 ± 8.6 | 74.0 ± 8.7 | 75.6 ± 8.6 | 78.3 ± 8.0 | 0.277 | ||||
| Range | 50–94 | 54–94 | 50–91 | 7–87 | ||||||
| Sex | Men | 129 | 70.9% | 58 | 74.4% | 66 | 68.0% | 5 | 71.4% | 0.658 |
| Women | 53 | 29.1% | 20 | 25.6% | 31 | 32.0% | 2 | 28.6% | ||
| Smoking | Yes | 107 | 58.8% | 45 | 57.7% | 58 | 59.8% | 4 | 57.1% | 0.957 |
| DM | Yes | 34 | 18.7% | 15 | 19.2% | 18 | 18.6% | 1 | 14.3% | 0.949 |
| HT | Yes | 103 | 56.6% | 44 | 56.4% | 55 | 56.7% | 4 | 57.1% | 0.999 |
| CVD (CAVD and/or CEVD) | Yes | 28 | 15.4% | 15 | 19.2% | 12 | 12.4% | 1 | 14.3% | 0.456 |
| Anticoagulant | Yes | 29 | 15.9% | 12 | 15.4% | 16 | 16.5% | 1 | 14.3% | 0.973 |
| Treatment | ||||||||||
| Type of anti-VEGF | Aflibercept | 123 | 67.6% | 50 | 64.1% | 70 | 72.2% | 3 | 42.9% | 0.191 |
| Ranibizumab | 59 | 32.4% | 28 | 35.9% | 27 | 27.8% | 4 | 57.1% | ||
| Regimen | PRN | 84 | 46.2% | 35 | 44.9% | 45 | 46.4% | 4 | 57.1% | <0.001 † |
| Modified TAE | 6 | 3.3% | 0 | 0.0% | 6 | 6.2% | 0 | 0.0% | ||
| TAE | 88 | 48.4% | 42 | 53.8% | 45 | 46.4% | 1 | 14.3% | ||
| Bimonthly | 4 | 2.2% | 1 | 1.3% | 1 | 1.0% | 2 | 28.6% | ||
| Switch | No | 147 | 80.8% | 59 | 75.6% | 82 | 84.5% | 6 | 85.7% | 0.353 |
| Anti-VEGF | 21 | 11.5% | 13 | 16.7% | 7 | 7.2% | 1 | 14.3% | ||
| PDT | 14 | 7.7% | 6 | 7.7% | 8 | 8.2% | 0 | 0.0% | ||
| PDT combined with initial treatment | Yes | 7 | 3.8% | 4 | 5.1% | 2 | 2.1% | 1 | 14.3% | 0.197 |
| Continuity * | Yes | 169 | 92.9% | 71 | 91.0% | 91 | 93.8% | 7 | 100.0% | 0.587 |
| No. injections | Mean ± SD | 5.4 ± 2.4 | 5.6 ± 2.38 | 5.2 ± 2.4 | 5.0 ± 2.1 | 0.887 | ||||
| Range | 1–3 | 1–11 | 1–13 | 2–8 | ||||||
| Simple Regression Model | Multivariate Regression Model | |||||||||
|---|---|---|---|---|---|---|---|---|---|---|
| Coef. | (95% Interval) | p > t | Coef. | (95% Interval) | p > t | |||||
| Background | Age (years) | 0.012 | 0.005 | 0.019 | 0.001 | 0.010 | 0.002 | 0.017 | 0.011 | |
| Sex | Men vs. women | 0.023 | −0.114 | 0.159 | 0.742 | |||||
| AMD subtype | PCV | 0 | - | - | - | 0 | - | - | - | |
| tAMD | 0.090 | −0.037 | 0.217 | 0.164 | 0.093 | −0.028 | 0.213 | 0.130 | ||
| RAP | 0.068 | −0.262 | 0.397 | 0.685 | −0.128 | −0.453 | 0.196 | 0.436 | ||
| Smoking | Yes vs. no | 0.111 | −0.014 | 0.236 | 0.081 | 0.164 | 0.042 | 0.286 | 0.009 | |
| DM | Yes vs. no | 0.155 | −0.003 | 0.312 | 0.054 | 0.214 | 0.060 | 0.369 | 0.007 | |
| HT | Yes vs. no | 0.074 | −0.051 | 0.199 | 0.243 | −0.074 | −0.200 | 0.052 | 0.249 | |
| CVD (CAVD + CEVD) | Yes vs. no | 0.128 | −0.043 | 0.299 | 0.140 | 0.047 | −0.117 | 0.211 | 0.573 | |
| Anticoagulant | Yes vs. no | 0.060 | −0.109 | 0.230 | 0.484 | |||||
| OCT findings | SRF | Yes vs. no | 0.016 | −0.178 | 0.210 | 0.869 | ||||
| IRF | Yes vs. no | 0.227 | 0.088 | 0.366 | 0.001 | 0.187 | 0.044 | 0.330 | 0.011 | |
| PED | Yes vs. no | 0.136 | 0.012 | 0.259 | 0.032 | 0.145 | 0.022 | 0.268 | 0.021 | |
| SHRM | Yes vs. no | 0.131 | 0.006 | 0.257 | 0.041 | 0.021 | −0.103 | 0.146 | 0.735 | |
| ERM | Yes vs. no | 0.192 | −0.231 | 0.614 | 0.371 | |||||
| HE | Yes vs. no | 0.116 | −0.013 | 0.246 | 0.078 | 0.034 | −0.092 | 0.159 | 0.597 | |
| SRH | Yes vs. no | 0.101 | −0.027 | 0.229 | 0.121 | 0.078 | −0.043 | 0.199 | 0.203 | |
| CRT | 0.000 | 0.000 | 0.001 | 0.195 | 0.0004 | −0.0002 | 0.001 | 0.190 | ||
| CCT | −0.001 | −0.001 | 0.000 | 0.106 | −0.0002 | −0.001 | 0.001 | 0.654 | ||
| Intervention | Anti-VEGF | A vs. R | 0.086 | −0.045 | 0.218 | 0.198 | 0.106 | −0.022 | 0.234 | 0.105 |
| regimen | PRN | 0 | ||||||||
| modified TAE | −0.158 | −0.511 | 0.196 | 0.380 | ||||||
| TAE | 0.067 | −0.060 | 0.195 | 0.298 | ||||||
| bimonthly | 0.091 | −0.337 | 0.519 | 0.676 | ||||||
| Switch | No | 0 | ||||||||
| Anti-VEGF | −0.016 | −0.212 | 0.179 | 0.869 | ||||||
| PDT | 0.061 | −0.173 | 0.296 | 0.607 | ||||||
| Frequency | Yes vs. no | −0.017 | −0.043 | 0.009 | 0.205 | −0.012 | −0.037 | 0.012 | 0.323 | |
| PDT | Yes vs. no | 0.039659 | −0.28302 | 0.362337 | 0.809 | |||||
| continuity | Yes vs. no | −0.076 | −0.316 | 0.165 | 0.536 | |||||
| LogMAR BCVA at baseline | 0.288 | 0.145 | 0.431 | 0.000 | 0.153 | −0.006 | 0.311 | 0.059 | ||
| Simple Regression Model | Multivariate Regression Model | |||||||
|---|---|---|---|---|---|---|---|---|
| Coef. | (95% Conf. | Interval) | p > t | Coef. | (95% Conf. | Interval) | p > t | |
| SRF | 46.4 | −6.6 | 99.3 | 0.086 | 38.4 | −13.7 | 90.5 | 0.148 |
| IRF | 30.6 | −8.4 | 69.6 | 0.123 | 19.7 | −19.4 | 58.7 | 0.321 |
| PED | −8.6 | −42.9 | 25.8 | 0.623 | −12.9 | −47.5 | 21.6 | 0.461 |
| SHRM | 33.3 | −1.4 | 67.9 | 0.060 | 32.7 | −3.0 | 68.4 | 0.073 |
| ERM | 192.2 | 79.3 | 305.0 | 0.001 | 179.1 | 65.9 | 292.3 | 0.002 |
| HE | 2.7 | −33.2 | 38.5 | 0.884 | −2.3 | −39.3 | 34.6 | 0.902 |
| SRH | 2.0 | −33.4 | 37.4 | 0.911 | −8.2 | −43.5 | 27.0 | 0.645 |
Disclaimer/Publisher’s Note: The statements, opinions and data contained in all publications are solely those of the individual author(s) and contributor(s) and not of MDPI and/or the editor(s). MDPI and/or the editor(s) disclaim responsibility for any injury to people or property resulting from any ideas, methods, instructions or products referred to in the content. |
© 2024 by the authors. Licensee MDPI, Basel, Switzerland. This article is an open access article distributed under the terms and conditions of the Creative Commons Attribution (CC BY) license (https://creativecommons.org/licenses/by/4.0/).
Share and Cite
Kominami, A.; Tomita, S.; Kato, A.; Ono, K.; Takeuchi, M.; Imazeki, M.; Terasaki, H.; Yamamoto, Y.; Jujo, T.; Wakuta, M.; et al. Factors Affecting Visual Acuity After Anti-Vascular Endothelial Growth Factor Therapy in Neovascular Age-Related Macular Degeneration: A Multicenter Study in Japan. J. Clin. Med. 2024, 13, 6244. https://doi.org/10.3390/jcm13206244
Kominami A, Tomita S, Kato A, Ono K, Takeuchi M, Imazeki M, Terasaki H, Yamamoto Y, Jujo T, Wakuta M, et al. Factors Affecting Visual Acuity After Anti-Vascular Endothelial Growth Factor Therapy in Neovascular Age-Related Macular Degeneration: A Multicenter Study in Japan. Journal of Clinical Medicine. 2024; 13(20):6244. https://doi.org/10.3390/jcm13206244
Chicago/Turabian StyleKominami, Aoi, Shuhei Tomita, Aki Kato, Koichi Ono, Masaru Takeuchi, Masaya Imazeki, Hiroto Terasaki, Yuki Yamamoto, Tatsuya Jujo, Makiko Wakuta, and et al. 2024. "Factors Affecting Visual Acuity After Anti-Vascular Endothelial Growth Factor Therapy in Neovascular Age-Related Macular Degeneration: A Multicenter Study in Japan" Journal of Clinical Medicine 13, no. 20: 6244. https://doi.org/10.3390/jcm13206244
APA StyleKominami, A., Tomita, S., Kato, A., Ono, K., Takeuchi, M., Imazeki, M., Terasaki, H., Yamamoto, Y., Jujo, T., Wakuta, M., Matsubara, H., Mitamura, Y., Kondo, M., Kimura, K., Takagi, H., Gomi, F., Sakamoto, T., & Yasukawa, T., on behalf of the Japan Clinical Retina Study (J-CREST) Group. (2024). Factors Affecting Visual Acuity After Anti-Vascular Endothelial Growth Factor Therapy in Neovascular Age-Related Macular Degeneration: A Multicenter Study in Japan. Journal of Clinical Medicine, 13(20), 6244. https://doi.org/10.3390/jcm13206244

